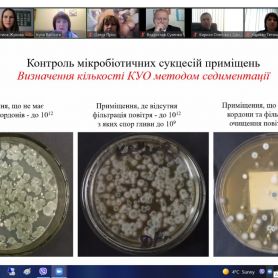
0-02-05-1c6df2b2a7e7536859cd2fa1a58f973addb48eb2169635d087f5c943df048ecd_87f90d97131e22b4

23 листопада 2021 року на базі двох кафедр: «Харчові технології та готельно-ресторанна справа», а також «Обладнання переробних і харчових виробництв імені професора Ф.Ю. Ялпачика», за співучасті громадської організації «Інтеркультурне гастрономічне коло» відбулась ІІ МІЖНАРОДНА НАУКОВО-ПРАКТИЧНА ІНТЕРНЕТ-КОНФЕРЕНЦІЯ «Новації в технології та обладнанні готельно-ресторанних, харчових і переробних виробництв».
В інтернет-конференції взяли участь 107 науковців з 14 вітчизняних та закордонних закладів освіти, серед них викладачі, здобувачі наукових ступенів, докторанти, аспіранти, магістранти та студенти, фахівці і керівники харчових, переробних підприємств, готелів і ресторанів.
У всіх представлених тезах розглядалися питання, актуальні для сучасного етапу розвитку харчової промисловості та готельно-ресторанної сфери. Робота інтернет-конференції проводилась за напрямками:
- Тенденції та перспективи розвитку обладнання харчових і переробних виробництв.
- Удосконалення процесів і технологій виробництва харчової продукції та переробки сільськогосподарської сировини.
- Проблеми безпеки та якості харчової продукції.
- Інновації підприємств готельно-ресторанної індустрії.
В результаті науково-практичної інтернет-конференції було проведено огляд найбільш актуальних питань і нових розробок.
Головна мета наукового заходу, спрямована на вирішення професійних і галузевих проблем харчової промисловості в ході професійного спілкування фахівців – досягнута. За підсумками роботи буде сформовано збірник матеріалів інтернет-конференції.
Інформаційний супровід: к.с.-г.н., доц. Жукова В.Ф.